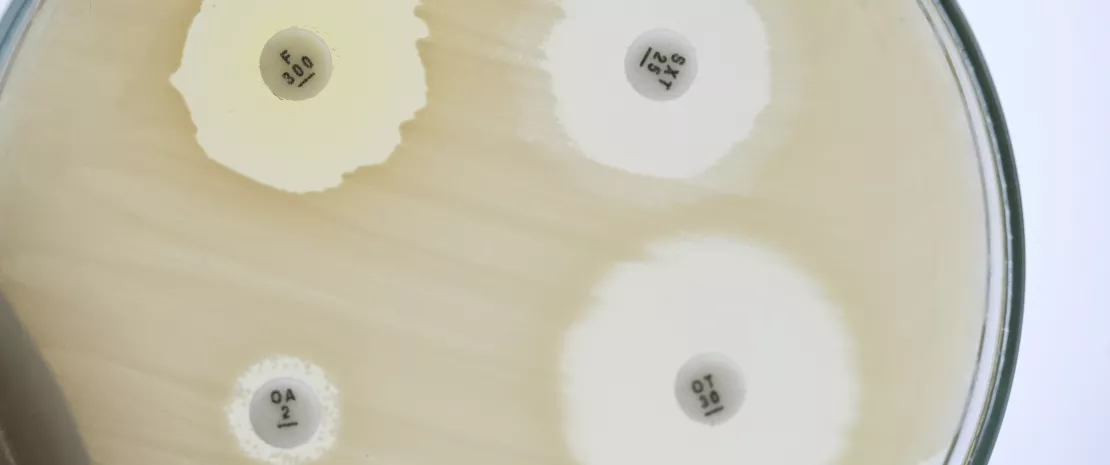

Descoberta uma "zona cinzenta" entre antibióticos bacteriostáticos e bactericidas inibitórios
Ao visarem tanto as bactérias patogénicas como as bactérias comensais, os antibióticos perturbam o equilíbrio da flora intestinal: estes efeitos secundários são bem conhecidos. Mas pouco se sabe sobre a ação de cada classe de antibióticos sobre as diferentes espécies bacterianas da microbiota intestinal. Um estudo publicado em Nature1 vem preencher essas lacunas.
Área para o público geral
Encontre aqui o seu espaço dedicado
en_sources_title
en_sources_text_start en_sources_text_end
Sobre este artigo
Os medicamentos exercem um forte impacto na microbiota. Especificamente, os antibióticos têm como alvo simultâneo as bactérias patogénicas e as comensais. São assim conhecidos por modificarem o equilíbrio da flora e causarem perturbações digestivas como diarreias e infeções por Clostridioides difficile. A mais longo prazo, podem fomentar alergias e distúrbios metabólicos. Para perceberem com maior precisão como as diferentes classes de antibióticos perturbam o equilíbrio microbiano intestinal, investigadores alemães analisaram o efeito de 144 antibióticos no crescimento e na sobrevivência de 27 microrganismos comensais, incluindo vários Bacteroides.
Três antibióticos bacteriostáticos com ação bactericida
Mediante a realização de 815 combinações entre antibióticos e espécies comensais, tiveram oportunidade de observar as diferenças de comportamento dos antibióticos em função da respetiva classe. Entre a 1.ª e a 4ª geração de quinolonas, por exemplo, o espectro de atividade alarga-se, inibindo na última quase todas as espécies comensais testadas. Os macrólidos inibem-nas a todas (salvo C. difficile). E 8 em cada 9 tetraciclinas inibem quase todas, o que é surpreendente, já que a microbiota intestinal é considerada um reservatório de genes de resistência às tetraciclinas. Mais surpreendente ainda, a eritromicina, a azitromicina e a doxiciclina, embora classificadas como bacteriostáticas, demonstraram rápido efeito bactericida em 12 espécies comensais em quase metade dos casos. A diminuição da sobrevida, superior a 99,9%, foi confirmada por um teste de viabilidade em Bacteroides vulgatus e numa estirpe de Escherichia coli.
Os antibióticos são uma descoberta científica extraordinária que salva milhões de vidas, mas a sua utilização excessiva e inapropriada tem agora suscitado sérias preocupações para a saúde, nomeadamente com a resistência aos antibióticos e a disbiose. Vejamos a sua página dedicada.
O papel ambivalente dos antibióticos
O que é a Semana Mundial de Conscientização sobre a RAM?
Todos os anos, desde 2015, a OMS organiza a Semana Mundial de Conscientização sobre a RAM (WAAW), que tem como objetivo aumentar a sensibilização para a resistência aos antimicrobianos a nível global.
Realizada entre 18 e 24 de novembro, esta campanha incentiva o público em geral, os profissionais de saúde e os decisores a utilizarem cuidadosamente os antimicrobianos, a fim de evitar o surgimento de uma maior resistência aos antimicrobianos.
Antídotos para minimizar o impacto dos antibióticos nas bactérias comensais
Estas observações colocam em causa, portanto, uma classificação bacteriostática/bactericida há muito estabelecida, ao mesmo tempo em que fornecem uma possível explicação para o poderoso efeito dos macrólidos na microbiota intestinal. Os investigadores não se limitaram a essa observação, pois passaram ao crivo a sua base de dados de 1.200 medicamentos para encontrarem moléculas com efeito de "antídoto" face à atividade bactericida da eritromicina e da doxiciclina nas bactérias comensais, mas que não impedissem a ação desses antibióticos sobre as bactérias patogénicas. Houve cerca de quinze moléculas que se mostraram interessantes. Os cientistas testaram-nas em diferentes concentrações num sistema microbiano sintético e num modelo animal contendo 12 espécies comensais. Resultado: dez moléculas permitiram evitar substancialmente as bactérias comensais, sendo as mais potentes o dicumarol, a benzobromarona e dois anti-inflamatórios não esteróides, o ácido tolfenâmico e o diflunisal.
O estudo vem assim lançar uma nova luz sobre a atividade dos antibióticos, ao mesmo tempo que sugere estratégias interessantes para a redução dos seus efeitos indesejáveis na microbiota intestinal.